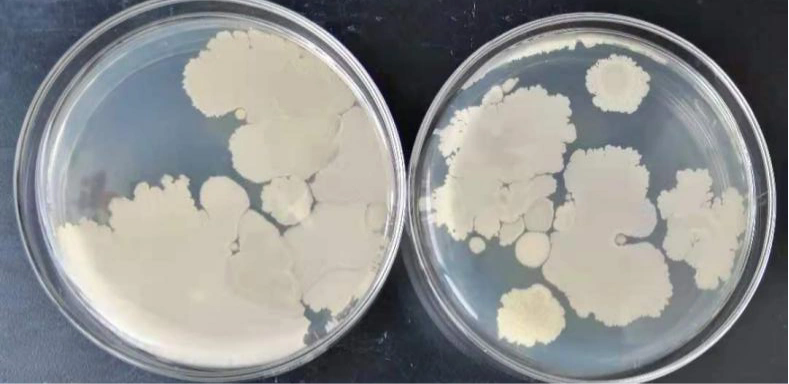

一、广州化妆品微生物检验员证书考试针对哪些人?
广州化妆品微生物检验员证书考试主要面向以下人群,覆盖化妆品行业全链条从业者及跨领域技术人才:
化妆品行业从业者
生产企业:质量检验员、生产技术员、研发人员,需掌握微生物检测以控制原料、半成品及成品质量。例如,某广州化妆品企业检验员需检测每批原料的菌落总数,确保符合《化妆品安全技术规范》要求。
销售与监管:销售企业质检员、市场监管人员,需理解微生物指标以评估产品安全性。如某电商平台质检员需核查供应商提供的微生物检测报告。
研发机构:配方工程师、安全性评估人员,需通过微生物检测验证产品防腐体系有效性。例如,某实验室需测试新配方防腐剂对金黄色葡萄球菌的抑制效果。
跨行业技术人才
食品/医药检验员:具备微生物检测基础的人员,可通过培训快速掌握化妆品领域技能。如某食品企业检验员转行后,需学习化妆品中铜绿假单胞菌的检测方法。
医疗器械检验员:熟悉无菌检测技术的人员,可拓展至化妆品无菌产品检验。例如,某医疗器械公司质检员需掌握化妆品车间洁净度沉降菌检测标准。
职业转型与兴趣人群
转行者:化学、生物、医学相关专业毕业生,或从事其他行业但希望进入化妆品质量领域的人员。
兴趣学习者:对化妆品安全感兴趣的非从业者,可通过考证提升专业知识。
二、广州化妆品微生物检验员考试形式与题型解析
考试分为理论考试与实践操作考试,全面评估考生的专业知识与实操能力。
理论考试
题型:选择题、填空题、判断题、简答题,部分考试可能包含案例分析题。
内容:
微生物学基础:细菌、霉菌、病毒的分类与特性,如革兰氏染色原理、微生物培养技术。
法规标准:化妆品行业法规,如《化妆品安全技术规范》中菌落总数限值(普通护肤类≤1000CFU/g)。
实验室安全:生物安全柜操作规范、危险化学品处理流程。
示例题目:
选择题:根据《化妆品监督管理条例》,化妆品生产企业的卫生许可证有效期为( )年。
A. 1 B. 3 C. 5 D. 10
简答题:简述化妆品微生物检测中菌落总数报告的规则。
实践操作考试
内容:
仪器操作:高效液相色谱仪(HPLC)用于防腐剂检测、PCR仪用于致病菌鉴定。
无菌操作:样品稀释、接种环灭菌手法。
检测技术:菌落计数(倾注平板法)、致病菌生化鉴定。
评分标准:操作规范性、结果准确性、时间控制。例如,倾注平板法中菌液体积超过1mL会导致菌落重叠,直接影响计数结果。
三、化妆品微生物检验员职业定义
化妆品微生物检验员是专门从事化妆品微生物与卫生理化检测的专业技术人员,其核心职责包括:理论学习:系统复习微生物学、法规标准、实验室安全知识,重点掌握化妆品领域特殊要求。
实操训练:通过模拟操作熟悉仪器使用与无菌技术,如接种环灼烧角度、培养基倾注手法。
真题练习:利用近3年考试真题熟悉题型与考点,例如菌落计数误差分析题常出现在简答题中。
机构选择:选择权威培训机构,如兰冠教育学院,其课程覆盖全行业检测技术,并提供就业指导服务。
结语
广州化妆品微生物检验员证书是进入化妆品质量安全领域的“敲门砖”,其考试内容紧密贴合行业需求,既考察理论基础,也注重实操能力。对于从业者而言,考取证书不仅是职业发展的助力,更是保障消费者安全、推动行业规范化的重要举措。
